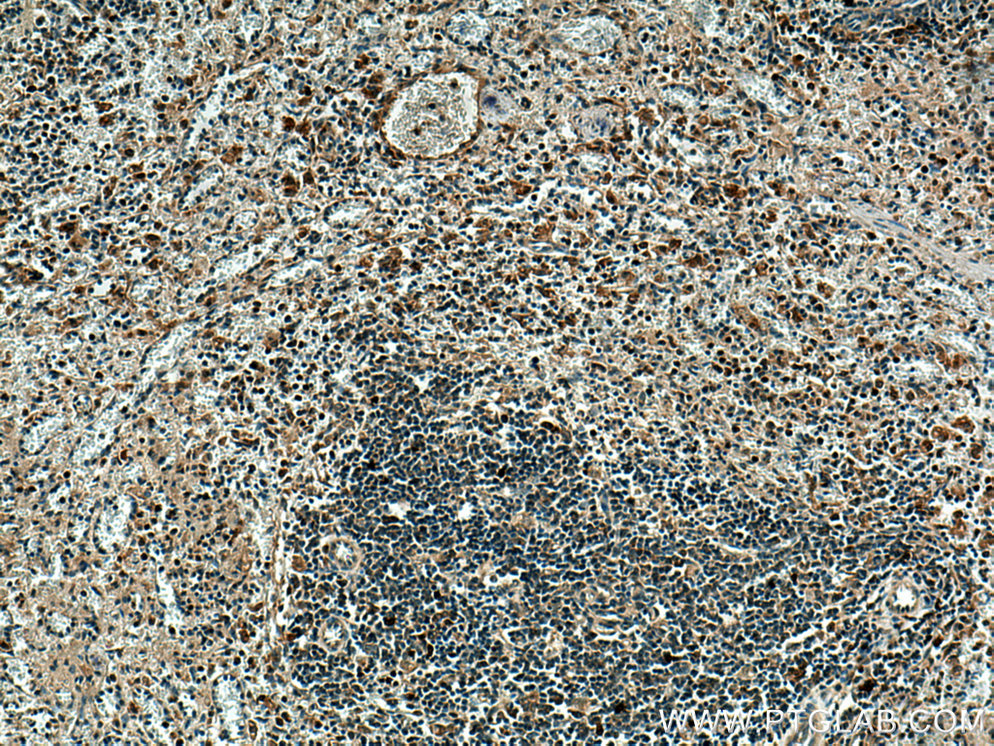

验证数据展示
经过测试的应用
| Positive WB detected in | THP-1 cells, U-937 cells |
| Positive IHC detected in | human tonsillitis tissue, human spleen tissue Note: suggested antigen retrieval with TE buffer pH 9.0; (*) Alternatively, antigen retrieval may be performed with citrate buffer pH 6.0 |
| Positive IF/ICC detected in | THP-1 cells |
推荐稀释比
| 应用 | 推荐稀释比 |
|---|---|
| Western Blot (WB) | WB : 1:1000-1:5000 |
| Immunohistochemistry (IHC) | IHC : 1:50-1:500 |
| Immunofluorescence (IF)/ICC | IF/ICC : 1:50-1:500 |
| It is recommended that this reagent should be titrated in each testing system to obtain optimal results. | |
| Sample-dependent, Check data in validation data gallery. | |
产品信息
28746-1-AP targets TNFR2/CD120b in WB, IHC, IF/ICC, ELISA applications and shows reactivity with human samples.
| 经测试应用 | WB, IHC, IF/ICC, ELISA Application Description |
| 文献引用应用 | WB, IHC, IF |
| 经测试反应性 | human |
| 文献引用反应性 | human |
| 免疫原 |
CatNo: Ag30490 Product name: Recombinant human TNFR2 protein Source: e coli.-derived, PGEX-4T Tag: GST Domain: 288-461 aa of BC052977 Sequence: KKKPLCLQREAKVPHLPADKARGTQGPEQQHLLITAPSSSSSSLESSASALDRRAPTRNQPQAPGVEASGAGEARASTGSSDSSPGGHGTQVNVTCIVNVCSSSDHSSQCSSQASSTMGDTDSSPSESPKDEQVPFSKEECAFRSQLETPETLLGSTEEKPLPLGVPDAGMKPS 种属同源性预测 |
| 宿主/亚型 | Rabbit / IgG |
| 抗体类别 | Polyclonal |
| 产品类型 | Antibody |
| 全称 | tumor necrosis factor receptor superfamily, member 1B |
| 别名 | TNFR2 / TNFRSF1B, TNFRSF1B, CD120b, Etanercept, p75 |
| 计算分子量 | 48 kDa |
| 观测分子量 | 75 kDa, 65 kDa |
| GenBank蛋白编号 | BC052977 |
| 基因名称 | TNFR2 |
| Gene ID (NCBI) | 7133 |
| RRID | AB_2881205 |
| 偶联类型 | Unconjugated |
| 形式 | Liquid |
| 纯化方式 | Antigen affinity purification |
| UNIPROT ID | P20333 |
| 储存缓冲液 | PBS with 0.02% sodium azide and 50% glycerol, pH 7.3. |
| 储存条件 | Store at -20°C. Stable for one year after shipment. Aliquoting is unnecessary for -20oC storage. |
背景介绍
Tumor necrosis factor-alpha (TNFA/TNFSF2) is a multifunctional cytokine that plays a key role in regulating inflammation, immune functions, host defense, and apoptosis (PMID: 16407280). TNFA signals through two distinct cell surface receptors, TNFR1 (TNFRSF1A, CD120a, p55) and TNFR2 (TNFRSF1B, CD120b, p75). TNFR1 is widely expressed, whereas TNFR2 exhibits more restricted expression, being found on CD4 and CD8 T lymphocytes, endothelial cells, microglia, oligodendrocytes, neuron subtypes, cardiac myocytes, thymocytes and human mesenchymal stem cells (PMID: 20489699; 22374304). In contrast to TNFR1, TNFR2 does not have a death domain. TNFR2 only signals for antiapoptotic reactions. However, recent evidence indicates that TNFR2 also signals to induce TRAF2 degradation (PMID: 22374304). Various defects in the TNFR2 pathway, due to polymorphisms in the TNFR2 gene, upregulated expression of TNFR2 and TNFR2 shedding, have been implicated in the pathology of several autoimmune disorders (PMID: 20489699).
实验方案
| Product Specific Protocols | |
|---|---|
| IF protocol for TNFR2/CD120b antibody 28746-1-AP | Download protocol |
| IHC protocol for TNFR2/CD120b antibody 28746-1-AP | Download protocol |
| WB protocol for TNFR2/CD120b antibody 28746-1-AP | Download protocol |
| Standard Protocols | |
|---|---|
| Click here to view our Standard Protocols |
发表文章
| Species | Application | Title |
|---|---|---|
PLoS Pathog SARS-CoV-2 spike-induced syncytia are senescent and contribute to exacerbated heart failure | ||
Oncol Lett Association between tumor necrosis factor receptor 2 and progression and poor prognosis of tumor stage 2‑3 esophageal squamous cell carcinoma and stratified analysis | ||
Front Immunol Integrating machine learning algorithms and multiple immunohistochemistry validation to unveil novel diagnostic markers based on costimulatory molecules for predicting immune microenvironment status in triple-negative breast cancer | ||
Am J Pathol TNF receptor-2 signals clear-cell renal carcinoma proliferation via phosphorylated-4EBP1 and mitochondrial gene translation |